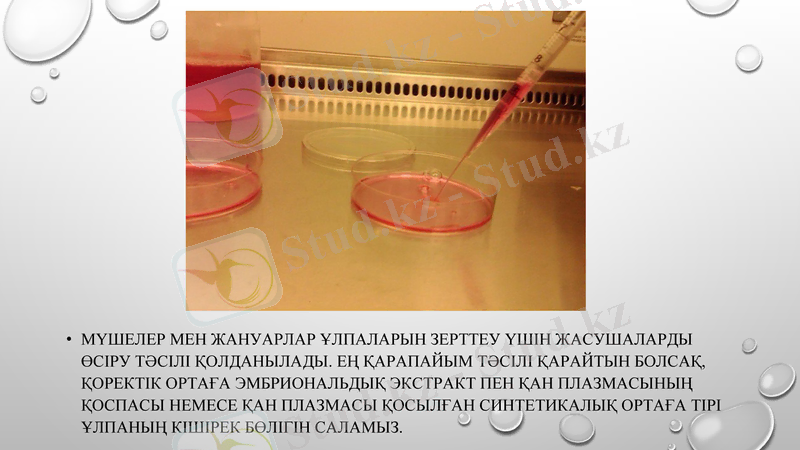
Slide 3
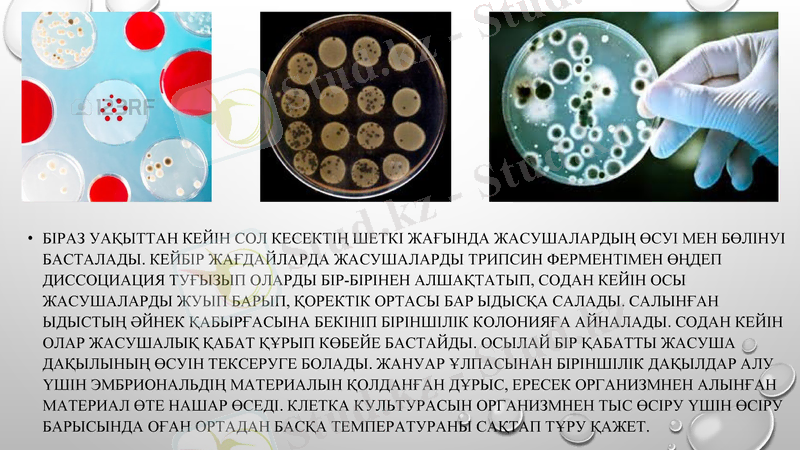
Slide 4

Жасуша культуралары: өсіру әдістері, микроскопиялық фототіркеу және уақыттық бейнелеу



Жасуша культурасы
Орындаған:

Жоспар:
Жасушаларды өсіру тәсілдері
Жасушалық культураларды зерттеулерде қолдану
Микроскоптың арнайы фото қондырғысы
цейтроферлі түсірілім
Пайдаланылған әдебиеттер
Мүшелер мен жануарлар ұлпаларын зерттеу үшін жасушаларды өсіру тәсілі қолданылады. Ең қарапайым тәсілі қарайтын болсақ, қоректік ортаға эмбриональдық экстракт пен қан плазмасының қоспасы немесе қан плазмасы қосылған синтетикалық ортаға тірі ұлпаның кішірек бөлігін саламыз.
Біраз уақыттан кейін сол кесектің шеткі жағында жасушалардың өсуі мен бөлінуі басталады. Кейбір жағдайларда жасушаларды трипсин ферментімен өңдеп диссоциация туғызып оларды бір-бірінен алшақтатып, содан кейін осы жасушаларды жуып барып, қоректік ортасы бар ыдысқа салады. Салынған ыдыстың әйнек қабырғасына бекініп біріншілік колонияға айналады. Содан кейін олар жасушалық қабат құрып көбейе бастайды. Осылай бір қабатты жасуша дақылының өсуін тексеруге болады. Жануар ұлпасынан біріншілік дақылдар алу үшін эмбриональдің материалын қолданған дұрыс, ересек организмнен алынған материал өте нашар өседі. Клетка культурасын организмнен тыс өсіру үшін өсіру барысында оған ортадан басқа температураны сақтап тұру қажет.

Қазір организмнен тыс жасушаны дақылдау әдісі тек цитологияда ғана емес, сонымен қатар генетикалық, вирусологиялық және биохимиялық зерттеулерде кеңінен қолданылады.

Дақылда өсімдік жасушаларында өсіруге болады. Ол үшін ұлпаның жасуша қабығын бір бөлігін ферментпен ерітеді. Бөлінген жасуша денесіндегі протопласттар дақылдық ортаға салынып, олар бөлінеді және жасуша зонасын құрады.

Тірі жасушаны қарауда әдетте микроскоптың арнайы фото қондырғысының көмегі арқылы жасалынған фотосурет түрінде тіркеледі. Тірі жасушаларды кинопленкаларға да түсіруге болады. Мұндай жағдайда осындай микросъемкалар кажетті ақпаратты береді. Тездетілген немесе баяулатылған киносъемканы қолдана отырып (цейтроферлі киносъемка) жасушаның қалай бөлінуі, фагоцитоз процесін, цитоплазма ішіндегі кірпікшелердің құрылуын және т. б. қажетті процестерді толық көруге болады.

Қазір компьютерлік технологияның дамуында арнайы жасушалар көмегімен тікелей компьютер мониторынан жасуша бейнесін көруге және оларды компьютерге жазуға болады. Қозғалмалы объектіні цейтроферлі түсірілім үшін компьютерлік көру қолданылады.

Қолданылған әдебиеттер:
«Жасуша биотехнологиясы», тұрашева с. қ., Алматы, 2011.
«биотехнология», жатқанбаев ж. ж., Алматы, 2009.
«Цитология және гистология», Сапаров Қ. Ә., Алматы: Қазақ университеті, 2009.
- Іс жүргізу
- Автоматтандыру, Техника
- Алғашқы әскери дайындық
- Астрономия
- Ауыл шаруашылығы
- Банк ісі
- Бизнесті бағалау
- Биология
- Бухгалтерлік іс
- Валеология
- Ветеринария
- География
- Геология, Геофизика, Геодезия
- Дін
- Ет, сүт, шарап өнімдері
- Жалпы тарих
- Жер кадастрі, Жылжымайтын мүлік
- Журналистика
- Информатика
- Кеден ісі
- Маркетинг
- Математика, Геометрия
- Медицина
- Мемлекеттік басқару
- Менеджмент
- Мұнай, Газ
- Мұрағат ісі
- Мәдениеттану
- ОБЖ (Основы безопасности жизнедеятельности)
- Педагогика
- Полиграфия
- Психология
- Салық
- Саясаттану
- Сақтандыру
- Сертификаттау, стандарттау
- Социология, Демография
- Спорт
- Статистика
- Тілтану, Филология
- Тарихи тұлғалар
- Тау-кен ісі
- Транспорт
- Туризм
- Физика
- Философия
- Халықаралық қатынастар
- Химия
- Экология, Қоршаған ортаны қорғау
- Экономика
- Экономикалық география
- Электротехника
- Қазақстан тарихы
- Қаржы
- Құрылыс
- Құқық, Криминалистика
- Әдебиет
- Өнер, музыка
- Өнеркәсіп, Өндіріс
Қазақ тілінде жазылған рефераттар, курстық жұмыстар, дипломдық жұмыстар бойынша біздің қор #1 болып табылады.



Ақпарат
Қосымша
Email: info@stud.kz